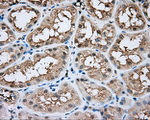
BTK Antibody in Immunohistochemistry (Paraffin) (IHC (P))

Search
OriGene
BTK Monoclonal Antibody (OTI3D11), TrueMAB™
{{$productOrderCtrl.translations['antibody.pdp.commerceCard.promotion.promotions']}}
{{$productOrderCtrl.translations['antibody.pdp.commerceCard.promotion.viewpromo']}}
{{$productOrderCtrl.translations['antibody.pdp.commerceCard.promotion.promocode']}}: {{promo.promoCode}} {{promo.promoTitle}} {{promo.promoDescription}}. {{$productOrderCtrl.translations['antibody.pdp.commerceCard.promotion.learnmore']}}
产品信息
CF501092
种属反应
宿主/亚型
分类
类型
克隆号
抗原
偶联物
形式
浓度
纯化类型
保存液
内含物
保存条件
运输条件
产品详细信息
For reconstitution, we recommend adding 100 µL distilled water to a final antibody concentration of about 1 mg/mL. To use this carrier-free antibody for conjugation experiments, we strongly recommend performing another round of desalting. (Zeba Spin Desalting Columns, 7KMWCO, 0.5 mL, Product # 89882)
靶标信息
Bruton tyrosine kinase (BTK) is a cytoplasmic tyrosine kinase belonging to the SRC-related TEC subfamily of tyrosine kinases. Mutations in the BTK gene have been linked to severe developmental blocks in human B-cell ontogeny and immunodeficiency disorders. It has recently been shown to interact with members of the toll-like receptor (TLR) family such as TLR4, 6, 8, and 9. The TLRs are critical molecules in both the innate and adaptive immunity and can recognize diverse microbial pathogens. BTK has also been shown to interact with key proteins involved in TLR4 signal transduction such as MyD88, TIRAP, and IRAK, but not TRAF-6, suggesting that BTK is involved in lipopolysaccharide signal transduction.
仅用于科研。不用于诊断过程。未经明确授权不得转售。
篇参考文献 (0)
生物信息学
蛋白别名: agammaglobulinaemia tyrosine kinase; Agammaglobulinemia tyrosine kinase; ATK; B-cell progenitor kinase; BPK; Bruton agammaglobulinemia tyrosine kinase; Bruton tyrosine kinase; Bruton's tyrosine kinase; dominant-negative kinase-deficient Brutons tyrosine kinase; MGC126261; MGC126262; OTTHUMP00000023677; RP1-164F3.2; truncated Bruton agammaglobulinemia tyrosine kinase; Tyrosine-protein kinase BTK; tyrosine-protein kinase BTK isoform (lacking exon 13 to 17); tyrosine-protein kinase BTK isoform (lacking exon 14)
基因别名: AGMX1; AT; ATK; BPK; BTK; IMD1; PSCTK1; XLA
UniProt ID: (Human) Q06187
Entrez Gene ID: (Human) 695